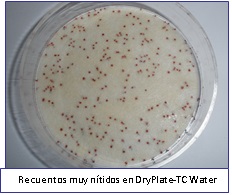
dryplates3

DryPlates® Placas preparadas de medio deshidratado
Placas preparadas de medio deshidratado; DryPlates. Absorben 1 ml directo de muestra o se siembra en estría tras prehidratar.
Las DryPlates® son placas preparadas estériles y listas para su uso
inmediato, con un año de caducidad gracias al hecho de estar elaboradas con medio deshidratado, que se hidrata precisamente mediante la muestra en el momento de inocularla. La gelificación en frío (a diferencia del Agar-agar, que precisa hervir para gelificar) se consigue con una mezcla sinérgica de gelificantes desarrollada por MICROKIT que denominamos “Hidragar” y que ahorra el hervido-fusión-enfriado-a-45ºC propios del medio clásico. El reparto de la muestra y la distribución homogénea del medio se consiguen gracias a un disco textil de malla muy fina, que retiene el medio de cultivo en polvo y la muestra, cuyo conjunto llamamos “Disco Nutriente”.
VENTAJAS SOBRE EL MEDIO CLÁSICO
-
- La muestra líquida (agua, bebidas…) o la solución madre y sus diluciones decimales (sólidos) se añaden directamente: 1 ml es totalmente autodifundido y absorbido en escasos segundos por cada placa (siembra en masa sin necesidad de fundir agares): Multiplica por 3-10 el límite inferior de detección/recuento de la placa preparada clásica, yaque ésta está destinada sólo para siembras en superficie de 0,1-0,3 ml. No necesita aplicadores. Unos medios difunden más rápidos que otros, pero es cuestión de segundos.

-
- Fácil y rápido manejo: de la muestra a la estufa en sólo 10 segundos!!! Ya no hay que autoclavar o fundir medios.
- Larguísima caducidad, de 12 meses desde fabricación.
- Recuentos muy evidentes, al emplearse medios cromogénicos y disco nutriente transparente, de fibra muy fina, que permite a las colonias desarrollarse sin las formas extrañas de otros kits. Incluso para los mohos invasivos, las colonias son muy nítidas.
- 100% estériles, al estar irradiadas por rayos gamma.
- Posibilidad de repicado de colonias, al ser más accesibles que en las placas clásicas, por ser el Hidragar mucho más blando que el Agar-agar.
-
MÁS VENTAJAS SOBRE EL MEDIO CLÁSICO
- La muestra se reparte por el medio con total homogeneidad y sin necesidad de aplicadores.
- Ahorro de espacio en almacenamiento, que es posible a
temperaturas muy variables (5-30°C), por lo que pueden guardarse en cualquier sitio; ahorro de espacio en las estufas de incubación: caben muchas más muestras en cada estufa que con la placa de 90; ahorro de volumen de material de desecho (compromiso medioambiental).
- Diseño para placa Petri de 55 mm: Máxima aceptación por los más ortodoxos microbiólogos, que no confían en otros formatos extraños en cartón, ni en otras placas que resultan demasiado pequeñas para un adecuado recuento.
- Gama completa de parámetros microbiológicos para alimentos, aguas y cosméticos.
- Versatilidad de empleo: 1 ml de muestra en masa o bien, tras
prehidratarlas con 1 ml de agua estéril: uso con membranas de Filtración para mayores volúmenes, uso en superficies con swabs, uso para control de aire…
- Validadas por MICROKIT con validaciones explicativas y disponibles al 100% (no sólo el diploma de la validación típico de otras entidades internacionales).
MODO DE EMPLEO
1. En las condiciones de asepsia propias de cualquier análisis microbiológico, voltear la placa de la DryPlates® y con unas pinzas, sacar un disco nutriente de su bolsa y colocar en la tapa.
2.Tomar la base de la placa (sin la tapa ni el disco nutriente), colocarla en su posición original y añadirle dentro 1 ml de muestra líquida (o su dilución) en el centro (no a los lados, ya que si la muestra toca la pared de la placa, tardará más en autodifundirse).
3.Voltear de nuevo la tapa con disco nutriente para volver a cerrar la placa, con cuidado para que el disco nutriente caiga centrado sobre la muestra; de este modo se repartirá homogéneamente en un instante:

Si se prefiere, tomar el disco nutriente con unas pinzas y colocarlo directamente sobre el ml de muestra, previamente dispensado en la placa):

4.Incubar en estufa, IMPORTANTE: en atmósfera húmeda (basta con dejar un vaso de agua lleno en la estufa), sin voltear las placas (el disco abajo) para que no se fugue nada de muestra durante la incubación. Las condiciones de incubación (tiempo y temperatura) son las estándar de cada medio y están indicadas en la etiqueta de su caja.
5.Leer los resultados (recuentos o aislamientos) buscando sólo las colonias diana, que crecen del color indicado para cada medio en el capítulo “GAMA” de este folleto (y en la etiqueta de su caja). Las demás colonias, si es que existen, no deben contarse, ya que son de flora acompañante o interferente.
6.Se puede aplicar el factor de corrección indicado en el CCC de cada medio, a fin de obtener el número de ufc/ml de muestra sembrada, como si fuera en placas clásicas de agar.
OTROS USOS
7.Para uso en aguas, añadir 1 ml de la muestra de agua en la placa TC-Water (con PCA Water-YEA-Nutrient Agar ISO 6222). En los demás parámetros del agua, y/o para mayores volúmenes, prehidratarlas poniendo 1 ml de agua estéril en la placa, añadir el disco nutriente y, una vez empapado, poner encima de éste la membrana filtrada.
8.Para uso con escobillones o para exponer al aire, añadir 1 ml de agua estéril a la placa para humectarla y colocar encima el disco nutriente, una vez empapado barrer sobre el mismo el escobillón con muestra o exponer al aire. Para exponer al aire añadir antes al agua 20 ml/litro de glicerol y una gota/litro de antiburbujas, para evitar el efecto desecación.
CONSERVACIÓN
- Almacenar a temperatura ambiente (ideal 15-25ºC) ¡no en nevera!, ya que en ésta la humedad es más fácil que prehidrate y estropee los discos nutrientes. Eso sí, es imprescindible almacenar en lugar muy seco y oscuro, ya que la humedad y la luz dañan irreversiblemente los medios de cultivo deshidratados. Si trabaja en zonas de alta humedad atmosférica, almacene las DryPlates®, bien cerradas en su bolsa, dentro de una caja hermética “tupper” con sacos antihumedad (ej: MICROKIT VRB747).
- El polvo seco que vea que se ha desprendido durante el transporte y almacenamiento es irrelevante y no afecta al resultado, ya que por el modo de fabricación, si se ha desprendido del disco nutriente, es que sobraba: el tejido mantiene siempre más de la cantidad mínima necesaria, por fuerzas electrostáticas y por la relación entre la granulometría del polvo y los intersticios del tejido.
-
PRECAUCIONES DE USO
- Algunas muestras, algunos medios y algunos diluyentes embeben peor que otros a causa de su diferente viscosidad y composición: si en unos segundos no se ha repartido homogéneamente toda la muestra en el disco nutriente, inclinar ligeramente la placa hasta que la muestra líquida sobrante vaya a un borde de la zona que aún no se haya hidratado y la empape (más trabajo da mezclar las siembras en masa de placas clásicas y esperar que se enfríen los agares).
- Si quedan “islas” grandes sin empapar y no desaparecen en menos de 1 minuto, es que se ha añadido algo menos de 1 ml de muestra (o que se ha añadido directamente una muestra viscosa sin diluir) y debería repetirse la prueba correctamente en otra DryPlate®.
- Este punto crítico de las micropipetas es más habitual de lo que se suele aceptar; y sólo gracias a las DryPlates®, se detecta antes de que sea demasiado tarde.
- Las islas secas pequeñas son irrelevantes, se autohidratan al incubar y no afectan los resultados (simplemente habrá calvas, pero todas las ufc habrán formado sus respectivas colonias).
- El añadir la muestra (o el agua de pre-humectación) sobre el disco nutriente, sea en el centro, sea repartiendo sobre su superficie, dificulta su autodifusión.
- Es mucho mejor dejar caer el disco nutriente sobre el ml de muestra centrada en la placa (o de agua de prehidratación), ya que es su propio peso el que facilita una perfecta autodifusión.
-
MÁS CUESTIONES
- Tener en cuenta que cada bolsa con 60 Discos Nutrientes es estéril en su interior, pero si se emplean algunos Discos Nutrientes sin terminar la bolsa, ésta debe almacenarse bien cerrada, con su saquito desecante y manipular en condiciones de asepsia, para evitar que entren contaminantes microbianos a la misma y provoquen resultados falsamente positivos en los siguientes análisis realizados con los Discos Nutrientes de dicha bolsa.
- Si la muestra es sólida o espesa, emplear la dilución madre (-1) y su serie de diluciones decimales preferiblemente en Agua de Peptona Tamponada Neutralizante MICROKIT: en polvo (DMT011), en tubos preparados 9 ml (TPL053S), en frascos 90 ml sin (RPL054) o con (RPL054P) perlas de vidrio para homogeneizar muestras espesas o bien en frascos 225 ml con perlas de vidrio (RPL228Z).
- Si no utiliza Agua de Peptona Tamponada Neutralizante como la indicada, y la muestra tiene conservantes (declarados/conocidos o no: cloro, formol, parabenes, ajo, pimentón, pimienta…), naturales o artificiales, los resultados pueden verse comprometidos y obtenerse grandes proporciones de resultados falsamente negativos, con este o con cualquier otro método de análisis microbiológico.
- Si el recuento (o concentración tras enriquecimiento en caldo) de los
microorganismos es muy alto, en vez de colonias diminutas podrían aparecer virajes globales de color del disco nutriente al color del medio diana (microcolonias muy apretadas entre sí), pero a veces muy tenue, por lo que podría pasar desapercibido e informarse de un falso negativo.
- Por ello en microbiología es importante realizar los recuentos en diversas diluciones decimales y contar las placas en la dilución que mejor se lean (las que tengan 10-200 colonias).
-
MÁS PRECAUCIONES DE USO
- El método clásico en agar-agar es el más robusto de cuantos existen en microbiología, ya que sirve para todo tipo de muestras en todo tipo de laboratorios. Los métodos modernos, como las DryPlates® y todos los demás, pueden tener limitaciones de uso en algunos tipos de muestras (ej. viscosas, grasas, hiperosmóticas…) y el usuario debe comprobar si funcionan correctamente en sus muestras concretas (validar), antes de aplicarlo de rutina.
- Algunos tipos de muestras pueden invitar a que se aplique un factor de corrección en los recuentos en DryPlates® para ser comparables con los resultados de las placas clásicas de agar-agar.
- Este número corrector lo calculará el laboratorio interesado comparando ambos métodos con sus productos. Por ejemplo, si para un producto en recuento de hongos obtiene en placa clásica una media de 90 colonias y en DryPlates® obtiene una media de 100, cuando ya implante el uso único de DryPlates®, multiplique el recuento obtenido en ellas por el factor de corrección (en este caso sería 90/100 = 0,9), para expresar el número de ufc/ml que habría en placa de agar clásico.
- Ej: Obtenemos 68 colonias en una DryPlates® YM-Food; 68 col x 0,9 = 61 ufc/ml de muestra sembrada, sería el recuento obtenido en placa clásica. Esta corrección sólo es necesaria si el factor de corrección es mayor a 1,5.
PRESENTACIÓN
Ofrecemos, para cada medio, dos tamaños de caja (60 u y 1200 u):
– cajas de 60 unidades (1 bolsa de 60 unidades junto a una caja pequeña de placas)
– cajas de 1200 (20 bolsas de 60 unidades junto a una caja grande de placas)

GAMA COMPLETÍSIMA
DryPlates® TC: DPP001- (caja 60 u) y DPP001+ (caja 1200 u) Recuento total de bacterias aerobias, medio color crema PCA ISO 4833 cromogénico, colonias rojas, se ven más rápido.
DryPlates® YM: DPP002- (caja 60 u) y DPP002+ (caja 1200 u) Recuento de hongos (levaduras y mohos), medio color rosa DGRBC Agar ISO 21527, colonias de sus colores naturales.
Y -DryPlates® TC-Water: DPP003 Recuento total en aguas, medio color crema YEA Nutrient Agar (PCA-Water) ISO 6222 cromogénico, colonias rojas.
También –DryPlates® SDA Caf: DPP021 Recuento de hongos (levaduras y mohos) en medicamentos y cosméticos, medio crema Sabouraud Dextrosa Agar Cloranfenicol Farmacopea, colonias de sus colores naturales.
Y TAMBIÉN PARA AISLAR PATÓGENOS
–DryPlates® EC: DPP006 Recuento de E.coli y demás coliformes.
–DryPlates® ETB: DPP008 Recuento de Enterobacterias, medio púrpura claro VRBG Agar ISO 21528, colonias púrpura oscuro.
Y también –DryPlates® STAPH: DPP009 Detección / Recuento de Staphylococcus aureus, medio crema CROMOKIT-STAPH Agar, colonias verde-azules.
–DryPlates® VIBRIO: DPP010 Detección / Recuento de Vibrio parahaemolyticus y de Vibrio cholerae, medio crema CROMOKIT-VIBRIO Agar, colonias verde-azuladas (V.parahaemolyticus) y púrpura (V.cholerae).
–DryPlates® BC: DPP011 Detección / Recuento de Bacillus cereus, medio salmón CROMOKIT-BC Mossel Agar, colonias con centro azul-verdoso.
Asimismo -DryPlates® SAL: DPP012 Detección de Salmonella, medio crema CROMOSALM Agar ISO 6579, colonias verde azuladas (el resto de enterobacterias crecen negras o incoloras).
-DryPlates® PS: DPP014 Detección de Pseudomonas aeruginosa, medio crema Cetrimida Agar ISO 22717/Farmacopea, colonias verdes, azules o amarillas, fluorescentes.
-DryPlates® BCPT: DPP015 Detección de Burkholderia cepacia, medio salmón BCPT Agar, colonias rosas o blancas (según cepa) con halo rosa.
Y –DryPlates® Candi: DPP016 Detección / Recuento de Candida albicans, medio crema CROMOKIT CANDIDA Agar, colonias verde-azuladas.
Placas preparadas de medio deshidratado; DryPlates. Absorben 1 ml directo de muestra o se siembra en estría tras prehidratar.
https://www.microkit.es/pdf/Dry-Plates-2021.pdf
ATENCIÓN: Si necesita mas información sobre las DryPlates® o necesita DryPlates® de otros medios rellene nuestro formulario de contacto http://www.medioscultivo.com/contacto/ o bien póngase en contacto con nosotros a través de nuestro correo electrónico microkit@microkit.es o por teléfono en el nº 91-897 46 16, y estudiaremos si podemos diseñarlas y fabricarlas para Ud.
https://www.microkit.es/monograficos/19-Monograf–a-Recuento-en-masa-sin-tener-que-perder-el-tiempo-fundiendo-agares.pdf
Haga sus consultas de este medio en: microkit@microkit.es
Haga sus pedidos de este medio en: pedidos@microkit.es
En este vídeo puedes entender mejor la hazaña de las DryPlates® y cómo usarlas:
https://www.youtube.com/watch?v=vkdRD5ulpSY&t=29s